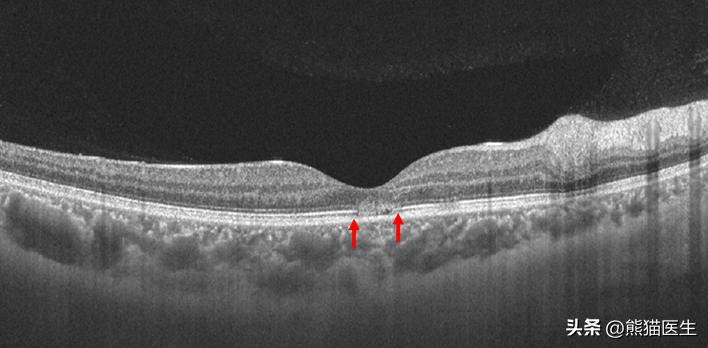
阳了一周之后眼睛模糊是后遗症吗,阳后出现眼部症状会怎样

最近,有不少网友表示,感染新冠病毒后,出现眼部酸痛、红肿、流泪甚至视物模糊等症状。在成都,也有人甚至因为新冠病毒感染,视力急剧下降。而据相关数据表明,新型冠状病毒感染患者出现眼部病变的比例为0%-35.71%。

感染新冠一周后
她的视力下降到0.02
日前,成都29岁的谢女士被查出感染了新冠病毒,除了出现发烧、咳嗽等,她在发热两天以后,还出现了双眼视力模糊、眼睛重影等症状。这种情况持续了一周都没有得到好转,甚至还有加重的趋势,无奈的她来到了四川省人民医院,找到了眼科副主任医师李杰医生。

检查发现,本来只是100度轻度近视的谢女士,左右眼视力分别下降到0.02和0.1,而根据WHO的标准,视力低于0.05就可以定义为盲。通过OCT以及眼底血管造影进一步检查,李杰医生发现谢女士黄斑区视网膜外层存在异常的高反射信号,这代表着局部可能存在炎症或者缺血改变。经过综合诊断,李女士的眼部疾病确诊为急性黄斑神经视网膜病变(AMN),属于一种眼科罕见病。
红色箭头处标记为病灶
针对谢女士的情况,李杰医生建议她进行入院治疗。经过两周的治疗,谢女士的双眼视力上升到了0.6,症状有了明显的好转,但是眼睛还有残留视物遮挡感。据李杰医生介绍,根据目前掌握的国内外文献数据来看,近一半左右的AMN患者都可能会有残留部分视力症状,即无法实现痊愈。
近一个月以来,李杰医生发现,门诊上,因为新冠病毒感染出现眼部疾病的患者越来越多,“最近1到2周,我们眼底病团队接诊或者会诊了30多例急性黄斑神经视网膜病变的患者。而在之前,全年也仅有1~2例患者。”李杰医生说,该疾病的患者以年轻人居多,女性多于男性,常常双眼发病,年龄一般在40岁以下。
新冠病毒感染会导致眼部疾病吗?
中华预防医学会公共卫生眼科学分会发布的《中国新型冠状病毒眼病防控专家共识(2022年)》指出,新型冠状病毒感染患者出现眼部病变的比例为0%-35.71%,多以结膜炎为首发病变。
此前,《自然·通讯》刊登的最新研究成果显示,新冠病毒可导致眼部不适和视网膜炎症。而《柳叶刀》发布的大型前瞻性观察研究也显示,即使接种过疫苗,仍有24.8%-27.7%的新冠感染者会出现眼睛酸痛的症状。
李杰医生表示,新冠病毒感染后出现因凝血状态改变、微血栓形成及炎症因子介导的血管收缩,导致视网膜局部炎症反应和/或缺血,引起视网膜病变,导致视力症状的发生。

感染之后眼睛有哪些症状?
新型冠状病毒眼病的临床表现多样,部分病人会出现结膜炎症状,如充血、水样分泌物、溢泪、瘙痒、异物感、眼痛、眼红、流泪、干眼等。
但也有极少一部分人会发生视力下降、事物模糊,事物变形,事物重影、眼睛有遮挡感等症状,比如急性黄斑神经视网膜病变。有些患者还可能出现视网膜分支动脉或者静脉的阻塞及视网膜大面积的出血。
李杰医生表示,新冠病毒感染引起的结膜炎症状,不必过于惊慌,一般在一周之内就能得缓解,特别是局部抗炎滴眼液对症治疗后。


眼部不适应该怎么办?
如果只是出现结膜等眼表组织的干涩或其他结膜炎症状,可以用非甾体类眼药水,例如普拉洛芬滴眼液、双氯芬酸钠滴眼液;如果是合并细菌感染有分泌物的,可以用抗生素滴眼液,例如托百士、左氧氟沙星滴眼液等。一般情况下,对症处理,症状都能得到有效缓解。
如果出现了视物模糊、视物变形等相关症状,要及时到有眼科的医疗机构就诊。眼红、眼痛等不适持续存在的患者也应该到医疗机构就诊。
李杰医生提醒,在日常生活中,应该要做好预防:
1.佩戴隐形眼镜的人群,可以戴框架眼镜,如若必须佩戴,建议在接触脸部之前,充分洗手。
2.要注意眼卫生、手卫生,包括勤洗手,避免触摸或揉眼睛,防止感染。当然,戴口罩、保持社交距离及尽量避免到人群密集的地方,对于目前处于疫情中的我们,是非常值得提倡的自我保护措施。
眼底视网膜病变
会带来严重危害
轻则视力快速下降,重则失明
如何才能早发现,早识别?
小康妹儿给大家带来了
四川省人民医院眼科
10个免费眼科或黄斑病变的检查福利
| 参与规则 |
① 黄斑病变自测
通过观察下图
可以进行自我鉴别
↓↓↓

可能存在以下六种情况
↓↓↓


如果有异常情况,则可能有黄斑病变,需要到医院做进一步检查。
② 关注“成都商报四川名医”微信公众号,公众号内回复口令“黄斑病变”,然后点击弹出链接,按指示填写信息即可。
如何知道自己是否中奖、入选?
若报名成功后,会有工作人员近期与您联系。所以,请报名后的朋友们注意留意手机噢~
本期科普医生

医生简介
从事眼科临床工作十余年,专注于眼底玻璃体视网膜疾病诊断与治疗及相关新技术的临床转化引用。擅长各类疑难眼底病及白内障诊治,包括复杂视网膜脱离、糖尿病视网膜病变、黄斑病变、视网膜变性、早产儿视网膜病变、高度近视眼底病变、其他各类玻璃体视网膜疾病、视网膜激光治疗及眼底荧光血管造影判读等。亦擅长其他眼科常见疾病诊治,如白内障、小儿屈光不正(近视/远视/散光)、眼外伤、青光眼及干眼症等。
门诊时间
周二全天

编辑 | wendy
监制 | 黄利琴
审核 | 蓝岚
图片来源 | 千图网